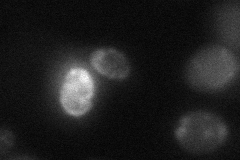
YCL027W
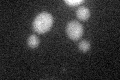
YCL027W

View description
Membrane protein localized to the shmoo tip, required for cell fusion; expression regulated by mating pheromone; proposed to coordinate signaling, fusion, and polarization events required for fusion; potential Cdc28p substrate
Localization:
Intensity:
Fold change:
Significance:
-
C’ GFP library in SD

below threshold15.92 -
N' NOP1pr-GFP in SD

ER32.2993 -
N' TEF2pr-mCherry in SD

ER,vacuole18.0364 -
N' NATIVEpr-GFP in SD

below threshold18.6312 -
N' TEF2pr-VC and Cyto-VN in SD
below threshold23.8932 -
C’ GFP library in SD+DTT
cytosol14.590.91No -
C’ GFP library in SD+H2O2

cytosol15.961No -
C’ GFP library in Starvation Media

cytosol17.331.08No -
C’ GFP library on the background of Pup2-DaMP

below threshold -
C’ GFP library on the background of CCT mutant

below threshold14.81470.930247No
